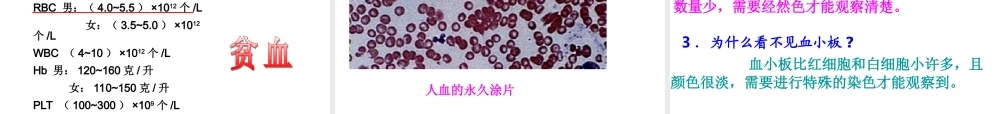
科学-技术-社会-干细胞和造血干细胞研究

第四章 人体内物质的运输第一节 流动的组织 ----- 血液 你平常感觉不到,你的身体里有一条条繁忙的运输线,它们将来自消化道的营养物质、来自肺部的氧气,迅速运往你身体的每一个细胞,同时将细胞生活中产生的废物及时运走
这些运输线就是遍布全身的大大小小的血管,血管里流动着血液
王威因失血过多不治而亡 王威因失血过多不治而亡 因失血过多不治而亡 对失血过多的病人及时输血 为什么失血过多会导致死亡
对失血多的病人,为什么要及时输血而不是输液
为什么通过化验血液能在一定程度上检查健康状况或诊断疾病
这都与血液的组成成分和功能有关
分析下面的资料
1 .将一定量的人的血液放入装有抗凝剂的试管中,用离心机离心或者静置一段时间后,可以观察到血液有明显的分层现象 ( 见右图 )
2 .人们到医院看病时,有时需要作血常规化验
病人血液成分的变化,可以作为对疾病作出诊断的参考
请阅读下面的血常规化验单,重点看“项目”和“测定值”这两栏
注:报告单中的 RBC 、 WBC 、 Hb 、 PLT 分别是红细胞、白细胞、血红蛋白和血小板的英文缩写
讨 论 :1 .含有抗凝剂的血液,离心或者静置一段时间后,为什么会出现分层的现象
血液中含有不同的组成物,它们的质量不一样,所以,含有抗凝剂的血液,离心或者静置一段时间后,就会逐渐分成上下两层以及中间一薄层白色物质
2 .综合上面的资料,你认为血液可能是由哪几部分组成的
常规化验单上所列的血液成分,分别应在什么层位
血液是由上层的淡黄色半透明液体,下层深红色部分以及中间的很薄的一层白色物质组成的
红细胞和所含的血红蛋白在下层的物质里,白细胞和血小板在中间很薄的一层白色物质里
为什么把血液称做“流动的组织”
血液中有大量的血细胞,这些细胞与血浆共同构成血液,完成物质运输等功能,因此血液是一种组织